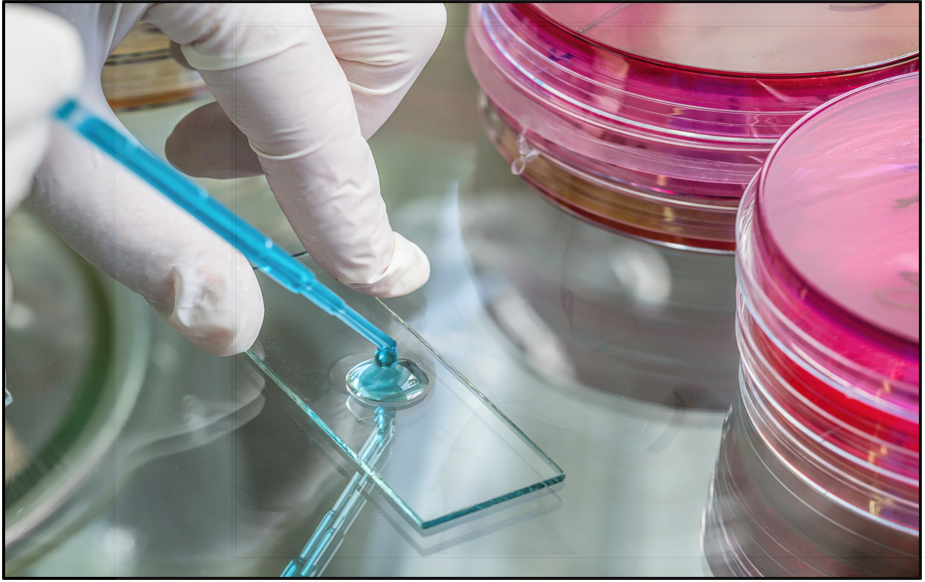
analisi legionella

Servizi di Prevenzione per la Legionella. Non esiste modo migliore di risolvere un problema di quello di non farlo accadere.
LA LEGIONELLA
Che cos’è?
Con il termine Legionella si intende un genere di batteri gram negativi aerobi di cui sono state identificate più di 50 specie. La più pericolosa è la Legionella pneumophila. Tali batteri sono presenti negli ambienti acquatici naturali e artificiali: nelle sorgenti, nei fiumi, laghi, vapori, terreni. Da questi essi risalgono a quelli artificiali come condotte cittadine e impianti idrici degli edifici (serbatoi, scaldabagni, tubature, fontane e piscine).
L’infezione da Legionella può dare luogo a due distinti quadri clinici: la Febbre di Pontiac e la Malattia del Legionario. La Febbre di Pontiac, che ha un periodo di incubazione di 24-48 ore, si risolve in 2-5 giorni ed è generalmente accompagnata da malessere generale e cefalee seguiti da febbre.
Le Conseguenze
La Malattia del legionario, invece, ha un periodo di incubazione medio di 5-6 giorni ed è molto più grave: oltre a malessere, cefalee e tosse, possono essere presenti sintomi gastrointestinali, neurologici e cardiaci e complicanze varie; nei casi più gravi può essere letale. Una polmonite da Legionella non si distingue da altre forme atipiche o batteriche di polmonite, ma è riconoscibile dalle modalità di coinvolgimento degli organi extra-polmonari.
L’uomo contrae l’infezione attraverso aerosol, cioè quando inala acqua in piccole goccioline (1-5 micron) contaminata da una sufficiente quantità di batteri; quando questa entra a contatto con i polmoni di soggetti a rischio, insorge la legionellosi, spesso in passato scambiata per una polmonite. Non è mai stata dimostrata la trasmissione per via contagiosa.
LA LEGIONELLA
Che cos’è?
Con il termine Legionella si intende un genere di batteri gram negativi aerobi di cui sono state identificate più di 50 specie. La più pericolosa è la Legionella pneumophila. Tali batteri sono presenti negli ambienti acquatici naturali e artificiali: nelle sorgenti, nei fiumi, laghi, vapori, terreni. Da questi essi risalgono a quelli artificiali come condotte cittadine e impianti idrici degli edifici (serbatoi, scaldabagni, tubature, fontane e piscine).
L’infezione da Legionella può dare luogo a due distinti quadri clinici: la Febbre di Pontiac e la Malattia del Legionario. La Febbre di Pontiac, che ha un periodo di incubazione di 24-48 ore, si risolve in 2-5 giorni ed è generalmente accompagnata da malessere generale e cefalee seguiti da febbre.
Le Conseguenze
La Malattia del legionario, invece, ha un periodo di incubazione medio di 5-6 giorni ed è molto più grave: oltre a malessere, cefalee e tosse, possono essere presenti sintomi gastrointestinali, neurologici e cardiaci e complicanze varie; nei casi più gravi può essere letale. Una polmonite da Legionella non si distingue da altre forme atipiche o batteriche di polmonite, ma è riconoscibile dalle modalità di coinvolgimento degli organi extra-polmonari.
L’uomo contrae l’infezione attraverso aerosol, cioè quando inala acqua in piccole goccioline (1-5 micron) contaminata da una sufficiente quantità di batteri; quando questa entra a contatto con i polmoni di soggetti a rischio, insorge la legionellosi, spesso in passato scambiata per una polmonite. Non è mai stata dimostrata la trasmissione per via contagiosa.
I FATTORI DI RISCHIO
Fumo
Immunodeficienza
Sesso Maschile
Patologie Cronico-Degenerative
Asma e Allergie
La Diffusione
Le installazioni che producono acqua nebulizzata, come gli impianti di condizionamento, le reti di ricircolo acqua calda negli impianti idrico-sanitari, costituiscono dei siti favorevoli per la diffusione del batterio.
Considerato che il range di proliferazione della Legionella va dai 15 °C a 50 °C (fino a 22 °C il batterio esiste ma inattivo), esistono delle zone critiche negli impianti idrosanitari: all’interno delle tubazioni, nei serbatoi di accumulo, nei bollitori, nei soffioni della doccia e nei terminali di distribuzione; anche gli idromassaggi, i sistemi idrici di emergenza, come le docce di decontaminazione, le stazioni di lavaggio per gli occhi e i sistemi sprinkler antincendio possono essere luogo di proliferazione.
Nelle reti idriche e aerauliche di tali edifici proliferano pericolosi Batteri che, se non correttamente gestiti, possono diventare patogeni per l’uomo e causare gravi malattie, anche letali. Prevenire questi rischi, oltre che per adempiere alle prescrizioni normative (D.LGS. 81/08, Linee guida per la Prevenzione e Controllo della Legionella, 2015), è di fondamentale importanza per Tutelare la Salute delle persone che transitano in tali ambienti.
FiMas è presente su tutto il territorio nazionale grazie ad una rete di Tecnici specializzati che eseguono analisi e valutazioni accurate del Rischio di Contagio Microbiologico. Per approfondimenti e consulenze gratuite sull’argomento potete contattare la nostra assistenza clienti al numero telefonico 06-52169091 o scriverci all’indirizzo mail info@fimasitalia.com
VALUTAZIONE E ANALISI RISCHIO LEGIONELLOSI
Gestione del Rischio
In caso di contaminazioni superiori ai limiti di legge, FiMas interviene con tecnici specializzati per la risoluzione del problema. In particolare, vengono effettuate complete sanificazioni di tutta la rete idrica (boiler, vasconi di accumulo, tubazioni, rompigetto) e aeraulica (UTA, split, fancoil), al fine di garantire la sicurezza degli impianti.
Analisi Legionella
I campionamenti dell’acqua e di superficie sono necessari per stabilire la situazione della diffusione della Legionella all’interno dell’impianto di distribuzione dell’acqua sanitaria/potabile e nell’impianto di condizionamento. Un corretto stato degli impianti, può essere certificato solo a valle di responsi analitici corretti, effettuati da laboratori accreditati.
Per l’impianto idraulico e aeraulico saranno eseguite analisi statisticamente rappresentative per la ricerca della Legionella, nei punti critici (Torri evaporative – UTA – Fancoil – Split – Boiler – Lavabi – Docce ecc.).
Per le metodiche di campionamento si adotterà il protocollo espresso nell’allegato 1 delle Linee guida per la prevenzione e il controllo della legionellosi – Gazzetta Ufficiale Numero 103 (Serie Generale) del 5 maggio 2000. Per la determinazione analitica della Legionella pneumophila si adotterà il protocollo espresso nell’allegato 2 delle sopracitate Linee Guida.
Le analisi saranno eseguite presso laboratorio ACCREDIA sulla specifica matrice. Su ciascun campione verrà effettuata la ricerca e determinazione quantitativa dei batteri appartenenti alla famiglia Legionella spp e si procederà contemporaneamente alla tipizzazione degli agenti appartenenti alla specie Legionella pneumophila e relativi siero gruppi.
Elaborazione Documento di Valutazione e Prevenzione Rischio Legionellosi
Personale tecnico specializzato eseguirà un accurato sopralluogo e uno studio tecnico attraverso:
- un’approfondita ispezione della struttura;
- l’acquisizione degli schemi degli impianti idrico sanitari e di condizionamento;
- i responsi analitici, precedentemente raccolti;
- la raccolta di informazioni in campo, per determinare la tipologia di frequentazione della struttura.
L’elaborazione di queste informazioni, unitamente alle indicazioni a contenimento del rischio, sarà contenuta in un unico Documento di valutazione dei Rischi derivanti dalla presenza di Legionella spp negli impianti idrici e aeraulici, in conformità a quanto previsto nel D.LGS. 81 DEL 9 aprile 2008 (Testo unico in materia di Tutela della Salute e della Sicurezza nei luoghi di lavoro).
Tale Documento indica:
- il grado di esposizione al rischio di contagio da patogeni,
- il programma di interventi immediati e di mantenimento, da porre in essere direttamente o tramite l’ausilio del Registro degli Interventi (“Linee guida per la prevenzione ed il controllo della legionellosi” della conferenza Stato-Regioni del 7 maggio 2015).
La valutazione del rischio legionella viene elaborata tramite un modello standard qualitativo che prevede di documentare e qualificare lo stato del singolo impianto. Questa metodica permette di valutare sia l’entità globale del rischio sia l’area dove occorre focalizzare gli sforzi per massimizzare la riduzione dei rischi associati alla legionella e ad altri agenti biologici.
Il rischio di contrarre la legionellosi si valuta in funzione di numerosi fattori che possono essere raccolti in tre principali gruppi:
- Potenziale di Popolazione Suscettibile (SPP) La probabilità dei soggetti ospitati nella struttura a contrarre patologie.
- Potenziale di Proliferazione (PP) La probabilità di sviluppo microbico all’interno dell’impianto.
- Potenziale di Esposizione all’Aerosol (AEP) La probabilità di esposizione ad aerosol contaminati.
Per i fattori 2 e 3 è possibile esprimere una valutazione in funzione del rischio intrinseco dell’impianto con i seguenti parametri:
- Alto: Sono presenti uno o più fattori in grado di aumentare il rischio.
- Moderato: Le condizioni non sono ottimali.
- Basso: Sono assenti fattori di rischio.
L’elaborazione di queste informazioni sarà contenuta in un unico documento definito Registro di Manutenzione Impianti, che attesterà lo sforzo dell’azienda a contrastare la diffusione della Legionella.
Tutta la documentazione prodotta (Documento Valutazione Rischio Biologico – Registro Attività preventive – Mappatura punti critici e rubinetti sentinella – Certificato di avvenuto intervento), oltre ad essere richiesta dalle vigenti normative come appendice del DVR generico, potrà essere usata in caso di accertamenti di organi preposti e avrà validità secondo gli usi di legge in materia.
VALUTAZIONE E ANALISI RISCHIO LEGIONELLOSI
Gestione del Rischio
In caso di contaminazioni superiori ai limiti di legge, FiMas interviene con tecnici specializzati per la risoluzione del problema. In particolare, vengono effettuate complete sanificazioni di tutta la rete idrica (boiler, vasconi di accumulo, tubazioni, rompigetto) e aeraulica (UTA, split, fancoil), al fine di garantire la sicurezza degli impianti.
Analisi Legionella
I campionamenti dell’acqua e di superficie sono necessari per stabilire la situazione della diffusione della Legionella all’interno dell’impianto di distribuzione dell’acqua sanitaria/potabile e nell’impianto di condizionamento. Un corretto stato degli impianti, può essere certificato solo a valle di responsi analitici corretti, effettuati da laboratori accreditati.
Per l’impianto idraulico e aeraulico saranno eseguite analisi statisticamente rappresentative per la ricerca della Legionella, nei punti critici (Torri evaporative – UTA – Fancoil – Split – Boiler – Lavabi – Docce ecc.).
Per le metodiche di campionamento si adotterà il protocollo espresso nell’allegato 1 delle Linee guida per la prevenzione e il controllo della legionellosi – Gazzetta Ufficiale Numero 103 (Serie Generale) del 5 maggio 2000. Per la determinazione analitica della Legionella pneumophila si adotterà il protocollo espresso nell’allegato 2 delle sopracitate Linee Guida.
Le analisi saranno eseguite presso laboratorio ACCREDIA sulla specifica matrice. Su ciascun campione verrà effettuata la ricerca e determinazione quantitativa dei batteri appartenenti alla famiglia Legionella spp e si procederà contemporaneamente alla tipizzazione degli agenti appartenenti alla specie Legionella pneumophila e relativi siero gruppi.
Elaborazione Documento di Valutazione e Prevenzione Rischio Legionellosi
Personale tecnico specializzato eseguirà un accurato sopralluogo e uno studio tecnico attraverso:
- un’approfondita ispezione della struttura;
- l’acquisizione degli schemi degli impianti idrico sanitari e di condizionamento;
- i responsi analitici, precedentemente raccolti;
- la raccolta di informazioni in campo, per determinare la tipologia di frequentazione della struttura.
L’elaborazione di queste informazioni, unitamente alle indicazioni a contenimento del rischio, sarà contenuta in un unico Documento di valutazione dei Rischi derivanti dalla presenza di Legionella spp negli impianti idrici e aeraulici, in conformità a quanto previsto nel D.LGS. 81 DEL 9 aprile 2008 (Testo unico in materia di Tutela della Salute e della Sicurezza nei luoghi di lavoro).
Tale Documento indica:
- il grado di esposizione al rischio di contagio da patogeni,
- il programma di interventi immediati e di mantenimento, da porre in essere direttamente o tramite l’ausilio del Registro degli Interventi (“Linee guida per la prevenzione ed il controllo della legionellosi” della conferenza Stato-Regioni del 7 maggio 2015).
La valutazione del rischio legionella viene elaborata tramite un modello standard qualitativo che prevede di documentare e qualificare lo stato del singolo impianto. Questa metodica permette di valutare sia l’entità globale del rischio sia l’area dove occorre focalizzare gli sforzi per massimizzare la riduzione dei rischi associati alla legionella e ad altri agenti biologici.
Il rischio di contrarre la legionellosi si valuta in funzione di numerosi fattori che possono essere raccolti in tre principali gruppi:
- Potenziale di Popolazione Suscettibile (SPP) La probabilità dei soggetti ospitati nella struttura a contrarre patologie.
- Potenziale di Proliferazione (PP) La probabilità di sviluppo microbico all’interno dell’impianto.
- Potenziale di Esposizione all’Aerosol (AEP) La probabilità di esposizione ad aerosol contaminati.
Per i fattori 2 e 3 è possibile esprimere una valutazione in funzione del rischio intrinseco dell’impianto con i seguenti parametri:
- Alto: Sono presenti uno o più fattori in grado di aumentare il rischio.
- Moderato: Le condizioni non sono ottimali.
- Basso: Sono assenti fattori di rischio.
L’elaborazione di queste informazioni sarà contenuta in un unico documento definito Registro di Manutenzione Impianti, che attesterà lo sforzo dell’azienda a contrastare la diffusione della Legionella.
Tutta la documentazione prodotta (Documento Valutazione Rischio Biologico – Registro Attività preventive – Mappatura punti critici e rubinetti sentinella – Certificato di avvenuto intervento), oltre ad essere richiesta dalle vigenti normative come appendice del DVR generico, potrà essere usata in caso di accertamenti di organi preposti e avrà validità secondo gli usi di legge in materia.